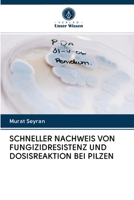
SCHNELLER NACHWEIS VON FUNGIZIDRESISTENZ UND DOSISREAKTION BEI PILZEN 6202902981 Book Cover
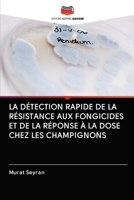
LA DÉTECTION RAPIDE DE LA RÉSISTANCE AUX FONGICIDES ET DE LA RÉPONSE À LA DOSE CHEZ LES CHAMPIGNONS 6202902973 Book Cover
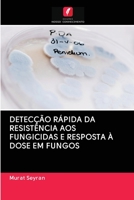
Detecção Rápida Da Resistência Aos Fungicidas E Resposta À Dose Em Fungos 6202902957 Book Cover
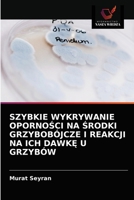
Szybkie Wykrywanie OpornoŚci Na Środki Grzybobójcze I Reakcji Na Ich DawkĘ U Grzybów 6202902922 Book Cover

Most Popular Books
- RAPID DETECTION OF FUNGICIDE RESISTANCE AND DOSE RESPONSE IN FUNGI: A CASE STUDY THE PECAN SCAB PATHOGEN FUSICLADIUM EFFUSUM
- SCHNELLER NACHWEIS VON FUNGIZIDRESISTENZ UND DOSISREAKTION BEI PILZEN
- Rilevamento Rapido Della Resistenza AI Fungicidi E Della Risposta Alla Dose Nei Funghi
- LA DÉTECTION RAPIDE DE LA RÉSISTANCE AUX FONGICIDES ET DE LA RÉPONSE À LA DOSE CHEZ LES CHAMPIGNONS
- Detecção Rápida Da Resistência Aos Fungicidas E Resposta À Dose Em Fungos